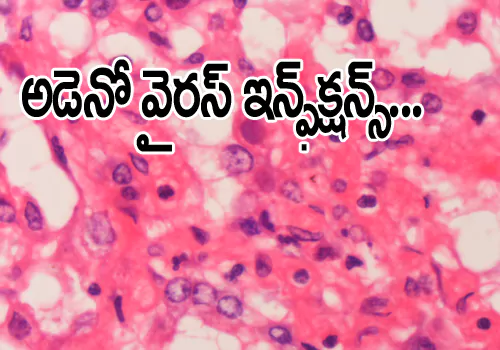

చిగుళ్లలో వచ్చే సమస్యలు అనారోగ్యానికి మూలమా??
నోరే సర్వరోగాలకి రహదారి అని ఒక వైద్యుడు అన్నారు.ఇది యాద్రుచికమో నిజమో తెలియదు కాని ఇటీవల్ బెర్మింగ్ హాం విశ్వ విద్యా లాయానికి చెందిన శాస్త్రజ్ఞులు నిర్వహించిన పరిశోదనలో చిగుళ్ళలో సమాస్యలు వస్తే రోగులకు ఇతర అనారోగ్య సమస్యలు ముఖ్యంగా మానసిక సమస్యలు, గుండె సమస్యలకు కారణం అవుతోంది. పిడియో డాన్టిక్ సర్జన్లు వెల్లడించారు. ప్రపంచం లో మొదటి సారి 64,౩79 రోగులపై జి పి ద్వారా నిర్వహించిన పరిశోదనలో పిడియో డాన్ట్రిక్స్ సమస్యల పై సమగ్ర అధ్యనం చేసారు.ఇందులో జింజు వైటిస్ ౩,౩84 మందికి పిడియో డాన్ ట్రిక్స్ సమస్యలు ఉన్నట్లు 251,161 మందిలో సమస్య లేనట్లు పేర్కొన్నారు.44 సంవత్సరాలు వయస్సు న్న వారిలో 4౩% పురుషులలో ౩౦% మంది పొగ త్రాగే వారు ఉన్నట్లు పరిశోధకులు గుర్తించారు. బి ఎం ఎస్ ప్రకారం సరైన బరువు లేకుండా అస్తవ్యస్తమైన శరీర ఆకృతిని కలిగి ఉన్నారు. పరిశోధకులు తమ పరిశోదనలో వచ్చిన సమాచారం లో వారిలో ఎంతమంది రోగులు దంత సమస్యలు,చిగుళ్ళ సమస్యలు లేకుండా ఉన్నారు. కార్డియాలజీ న్యూరో వ్యాస్క్యులర్ సమస్యలు అంటే గుండె పోటు, గుండె ఆగిపోవడం,వాస్క్యులర్ డి మ్నీషియా, లేదా కార్డియో మెటాబాలిక్ డిజార్దర్ ఆటో ఇమ్యూన్ కండి షన్స్,ఆర్త రైటిస్ ,టైప్ 1, డయాబెటిస్ సోరియాసిస్, మానసిక అనారోగ్యం ఇన్ని సంవత్సరాలలో ఎన్నిసార్లు చికిత్సలు చికిత్సలు చేయించుకున్నారు.వాటి చరిత్ర,వంటి అంశాల పై బి ఎం జ జర్నల్ లో ఈ పరిశోదన అంశాలను ప్రచురించారు. దంత సంబందిత,సమస్యతో బాధ పడుతున్నారా? వారి చరిత్ర ఆధారంగా పరిశోదన తొలి రోజునుండి అదనపు సమస్యలు వస్తూనే ఉన్నాయి. మూడు సంవత్సరాలుగా దంత సమస్యలతో ఉన్న వారు ౩7% మంది మానసిక అనారోగ్య సమస్యలతో బాధ పడుతున్నారని,ఆటో ఇమ్యూన్ డిజార్దర్ తో౩౩% కార్డియో వాస్క్యులర్ సమాస్యలర్ సమస్యలతో 7%అత్యధికంగా చక్కర వ్యాధితో ఉన్న వారు 26% ఉన్నట్లుగా గుర్తించారు. బర్మింగ్ హాం విశ్వవిద్యాలయానికి చెందిన పరిశోదన గ్రంధ కర్త డాక్టర్ జొహ్ట్ సింగ్ చందన్ ఈ అంశం పై విశ్లేషిస్తూ నోటి ద్వారా వచ్చే అనారోగ్య సమస్యలు రావడం సహజమే అని అన్నారు. నోటి కి సంబందించిన ఆరోగ్య సంరక్షణ దంత సంరక్షణ ను నిర్లక్షం చేయడం వల్లే తీవ్ర అనారోగ్య సమస్యలలో భాగంగా ప్రజలు నాణ్యతతో కూడుకున్న జీవన ప్రమాణాలు దిగాజారాయని నిపుణులు విశ్లేషిస్తున్నారు. ఏది ఏమైనప్పటికీ ఇప్పటికే నోటి ద్వారా వచ్చే అనారోగ్యమే ఇతర దీర్ఘకాలిక అనారోగ్యానికి కారణం అన్న అంశం పై ఇంకా పూర్తి స్థాయి పరిశోదన వివరాలు అందాల్సి ఉందని అన్నారు.మరిన్ని పరిశోదనలు జరగాల్సిన అవసరం ఉందని అభిప్రాయ పడ్డారు. బర్మింగ్ హాం విశ్వ విద్యాలయం నేషనల్ నేషనల్ ఇన్స్టిట్యుట్ ఆఫ్ హెల్త్ బయో మెడికల్ రీసెర్చ్ ఈ పరిశోదనలో పాల్గొన్నాయి. ఆటో ఇమ్మ్యున్ డిజార్దర్ మదటిది దీనిని రోమటైడ్ ఆర్తరైటిస్ తో 4,౦౦౦౦౦ మండికి యు కే లో తీవ్ర సమస్యగా మారింది. రోమటైద్ ఆర్తరైటిస్ ఉన్న వారిలో మూడు ఇంతలు తీవ్రంగా ఉందని,రోమటైద్ ఆర్తరైటిస్ లేని సమాజంగా తయారు చేయాలనీ ఆశిస్తున్నారు. దంత సమస్యలు,చిగుళ్ళ సమాస్యలకు హోలిస్టిక్ అప్రిచ్ అఫ్ నేదిసిన్ అవలంభించాలని పేర్కొన్నారు.
read moreమూత్ర,రక్త పరీక్షలు ఆరోగ్యం గురించి తెలుసుకోవచ్చు...
మీ మూత్ర,రక్త పరీక్షలను అర్ధం చేసుకోవాలి. అది మీ ఆరోగ్యం లో ఉండే వ్యాధి తీవ్రతను,సమస్యను చెప్పేస్తాయి. మీ మూత్ర,రక్త పరీక్షలు చేసినప్పుడు వచ్చే ఫలితాల ను ఎలా అర్ధం చేసుకోవాలి? మీ మూత్ర,రక్త పరీక్ష మీ గుండె సంబందిత వ్యాధిని గుర్తిస్తుందన్న విష యం మీకుతెలుసా ? ఆవిషయం మాకూ తెలుసు అంటారా? త్ఘేలుసు అయితే ఒక్కోపరీక్ష దేనికి చేస్తారు వాటి అవసరం ఏమిటి అన్న విషయం పూర్తిగా అవగాహన కల్పించే ప్రయాత్నం చేస్తున్నాం. మీకు లిపిడ్ ప్రొఫైల్ పరీక్ష రాశారా ?... లిపిడ్ ప్రొఫైల్ ద్వారా మీ రక్తం లో కొలస్ట్రాల్ శాతం ఎంత ఉందొ తెలుస్తుంది. ఆరోగ్యం గా ఉన్న పెద్దవాళ్ళలో అయితే హెచ్ డి ఎల్ కొలస్త్రాల్ స్థాయి 2౦౦ ఎం పి లోపు ఉండాలి మంచి హెచ్ డి ఎల్ ఒక వేళ శాతం తగ్గిన గుడ్ కొలస్త్రాల్,లేదా బ్యాడ్ కొలస్ట్రాల్ మీ రక్త నాళాలను అడ్డుకుంటాయి.మీ ఎల్ డి ఎల్ 1౦౦% లోపే ఉంచుకోవాలని,హెచ్ డి ఎల్ 6౦% పైనే ఉండాలని వదిద్యులు సూచిస్తున్నారు. ట్రై గ్లిసరైడ్స్ పరీక్ష అంటే... మీ శరీరంలో ట్రై గ్లిసరైడ్స్ మీ ఆర్తరైటిస్ ను మరింత పెంచుతాయి.ట్రై గ్లిసరైడ్స్ పెరిగాయో అది మీ గుండె సమస్యకు కారణం కావచ్చు. స్ట్రోక్స్,హార్ట్ ఎటాక్స్, హై బిపి బ్లడ్ ప్రెషర్ సమాస్యలు వస్తాయి. ఆరోగ్యం గా ఉన్న పెద్దవాళ్ళలో 12 గంటల పాస్టింగ్ లో డి ఎల్ 15౦ ఎంజి.కన్నా తక్కువ ఉండాలి (అంటే 1౭ ఎం ఎం ఓ ఎల్ ) 15౦ నుండి 199 బోర్డర్ లైన్ లో ఉండాలి అంటే (17. 22 ), హై డి ఎల్ 2౦౦ నుండి 499 ఎం జి (అంటే ౩.56 )ఎం ఎం ఎల్. వెరి హై గ్రేడ్ 5౦౦ ఎం జి ( అంటే 56 ఎం ఎం ఎల్ ) లిపిడ్ ప్రో ఫైల్ ఎవరికీ అవసరం ?... 2౦ సంవత్సరాలు పై బడిన ప్రతి ఒక్కరికి 4-6 సంవత్సరాలకు ఒకసారి లిపిడ్ ప్రొఫైల్ చేసుకోవాలి. కాగా పిల్లలో 9సమవత్సరాలకు 17-21 సంవత్సరాల మధ్య ఒక్కోసారి హై కొలస్త్రాల్,ట్రై గ్లిజరాయిడ్స్ ముఖ్యంగా యుక్త వయస్సులో అంటే టీన్ ఏజ్ లో ఉన్నవారిలో ప్లాక్స్ పెరిగే అవకాశం ఉంది.ఒక వేళ మీకు తీవ్ర అనారోగ్యం లేదా కొలస్త్రాల్ అత్యధికంగా ఉన్న హార్ట్ ఎట్టాక్ ఉండే ప్రమాదం ఉంటటే తరచుగా పరీక్షలు నిర్వహించమని డాక్టర్ సూచిస్తాడు.హై కొలస్ట్రాల్ అంగీకార యోగ్య మైనదిగా ఉంటె చాలా మందిలో 19 నుండి 17౦ ఎం జి డి ఎల్ గా ఉండే అవకాశం ఉంటుంది కొలస్ట్రాల్ ను అదుపులో ఉంచుకుంటే సమస్య రాకుండా ఉండాలని పేర్కొన్నారు. బ్లడ్ షుగర్ టెస్ట్... శరీరంలో కొన్ని అనారోగ్యాలకు మూలం శరీరంలో రక్త్ఘం లో చక్కర శాతం పెరగడం ప్రధాన కారణంగా వైద్యులు నిర్ధారిస్తారు. మీ శరీరంలో గ్లూకోజ్ అత్యధిక శాతం ఉంటె పరీక్షించడం అవసరం. లేదా హైపర్ గ్లైసీమియా డయాబెటీస్ కు సంకేతం. మీరు ఆరోగ్యంగా ఉంటె గ్లూకోజ్ శాతం 1౦౦ లోపే ఉంటె ఒకవేళ డి ఎల్ 12౦ పైన ఉంటె మీ డయాబెటీస్ ఉన్నట్లే. గ్లూకోజ్ శాతం ర్యండం బ్లడ్ షుగర్ ను 2౦౦ ఎం జి పైన ఉంటె హై డయాబెటీస్ ఇంకా తక్కువ ఉంటె మీ మెడకు ప్రమాదం లేదా ఇతర అనారోగ్య సమస్యల కు దారి తీస్తుంది. రక్తం లో హిమాగ్లోబిన్ పరీక్ష ఏ ఐ సి... ఈ పరీక్ష ద్వారా మీ రక్త్ఘం లో చక్కర శాతం రక్తం లో గ్లూకోజ్ ను పరీక్షిస్తారు. 2- లేదా ౩ నెలల మధ్య కలాం లో ఎవరేజ్ బ్లడ్ షుగర్ ను పరీక్షిస్తారు. ఆరు రోజులుగా మీ రక్తం లో హై గ్లూకోజ్ స్వింగ్ చూపుతుంది. ఇందులో ఎర్ర రక్త కణాలు,చక్కర శాతం,రక్త కణాల శాతం, అది మీరు ఆరోగ్యంగా ఉన్నారా లేదా అన్న విషయాన్ని తెలుపు తుంది. ఎర్రె రక్త కణాల శాతం 5.7 %అంటే 7 %లోపే నియంత్రించాలని వైద్యులు సూచిస్తారు. యూరిన్ ఎనాలసిస్... మీరు చేయించే మూత్ర పరీక్ష మీ ఆరోగ్యం గురించి చెపుతుంది.మీ మూత్రం రంగు, పి హెచ్ శాతం లెవెల్,కీటోన్స్ లెవెల్,బ్యాక్టీరియా లేదా ఇతర అనారోగ్య సమస్యలు. తెలియ చేస్తుంది. మీరు గర్భిణీ లుగా ఉన్నవారైనా, సర్జరీ అయిన వారికి,మూత్రంలో యురినరీ ట్రాక్ ఇన్ఫెక్షన్,ఉన్నవారికి కిడ్నీ సమస్యలు ఉన్నవారికి మూత్ర పరీక్ష తప్పని సరి.ముఖ్యంగా చక్కేర వ్యాధి ఉన్న వారికి యురిన్ లో ప్రోటీన్ పోతూ ఉంటుంది లేదా ఎర్ర రక్త కణాలు పోతున్న మూత్ర పరీక్ష చేయించమని డాక్టర్లు సూచిస్తారు. కంప్లీట్ బ్లడ్ కౌంట్ పరీక్ష ... మీ రక్తం లో బ్లడ్ కౌంట్ ను పూర్తిగా పరీక్షిస్తారు. ఎర్రరక్తకణాలు,తెల్ల రక్త కణాలు మీ ఆరోగ్యానికి సంబందించిన పూర్తి ముఖ చిత్రం చూపిస్తుంది. రక్త కణాలలో ఎలాంటి కండీషన్స్ ఉన్నాయో తెలుస్తుంది. ముఖ్యంగా ఇన్ఫెక్షన్స్, ఎనీమియా, రక్త హీనత క్యాన్సర్ పరీక్షలు నిర్వహిస్తారు. ఎర్ర రక్త కణాల పూర్తి కౌంట్... శరీరానికి ఆక్సిజన్ ఇచ్చి కణాలకు జీవాన్ని ఇచ్చేది ఎర్రరక్తకణాలే మీ శరీరం లో ఎర్ర రక్తకణాలు తగ్గాయి అంటే మీరు మీ ఆహారంలో సమతుల పౌష్టిక ఆహారం తీసుకోవడం లేదని అర్ధం అని నిపుణులు పేర్కొన్నారు. ఎక్కడైనా శరీరంలో రక్త శ్రావం జరిగితే లేదా బోన్ మ్యారో సమస్యలు ,గుండె సమస్యలు లేదా ఊపిరి తిత్తుల సమస్యలు ఇతర సమస్యలు పురుషులలో రక్త కణాలు 45 నుండి 59 మిలియన్ల సెల్ల్స్ ఉంటాయి. స్త్రీలలో 41 మిలియన్ల అంటే 5 లక్షల ఉన్నట్లు గా గుర్తిస్తారు. తెల్ల రక్త కణాలు... తెల్ల రక్త కణాల కౌంట్ ఉంటె దాని ఆర్ధం మీరు ఇన్ఫెక్షన్ తో పోరాడుతున్నట్లు లెక్ఖ.ఎలర్జీ,ఇంఫ్లామేషణ్,లేదా తక్కువగా ఉంటె బోన్ మ్యారో సమస్యలు అయ్యి ఉండవచ్చు. లేదా మీ ఇమ్మ్యున్ సిస్టం ఉదాహరణకు పోషక విలువలు లేని ఆహారం,ఒత్తిడి,ఆధిక వ్యాయామం,వల్ల కూడా తెల్ల రక్త కణాల సంఖ్య తగ్గవచ్చు.కాగా పురుషులలో ౩46 బిలియన్లు 9.6 బిలియన్ల సెల్ల్స్ ఉంటాయని ఆయా రక్త కణాల సాంఖ్య ను గుర్తించ వచ్చు. ధైరాయిడ్ స్టిమ్యులేషన్ హార్మోన్ పరీక్ష... మన శరీరంలో ధైరాయిడ్ గ్రంధి పెరిగితే లేదా గొంతు చుట్టూ వాపు ఉంటె శరీరంలో పల్స్ బీట్ అధికంగా కొట్టుకుంటే అమాంతం బరువు పెరగడం ధై రాయిడ్ వల్ల ఓవర్ ఆక్టివ్ కావడం లేదా ధైరాయిడ్ తక్కువగా ఉండడం చర్మం పై దద్దుర్లు.ఎండిపోయి నట్లు ఉండడం.మల బద్ధకం ఇతర మందులు అంటే మల్టి విటమిన్ మందుల వాడకం లేదా ఇతర సమస్యలు గురించి చర్చించండి. ప్లేటి లేట్ కౌంట్... రక్తనాళాలలో మీ శరీరంలో ఉన్న గాయాలను మానేట్లు చేస్తాయి.శరీరంలో అత్యధికంగా ప్లేటి లేట్లు ఉండడం ప్రామాదకరం. దీనివల్ల మీ చేతులలో కాళ్ళలో రక్తం గడ్డ కట్టడం, రక్తం రక్త నాళాలలో గడ్డ కడితే గుండె సమస్యలు వస్తాయి.ప్లేతిలేట్ల కౌంట్ మీ చిగుళ్ళ నుండి రక్త స్రావం వల్ల ప్లేటి లెట్స్ పడిపోవచ్చు, ముక్కు,పొట్ట ద్వారా లేదా బోన్ మ్యారో అనారోగ్యం లేదాడెంగు వంటి వైరల్ ఇన్ఫెక్షన్ వల్ల ప్లేటి లేట్లు, కౌంట్ పడిపోయే అవకాశం ఉంది. ఆల్కాహాల్ అలవాటు ఉన్నవారికి ప్లేటిలేట్లు కౌంట్ ప్సదిపోయే ప్రామాడం ఉంది. సహజంగా వ్యక్తిలో ప్లేటిలెట్లు 1,5౦,౦౦౦ నుండి 4,5౦.౦౦౦. ప్లేటిలేట్స్ ఉంటాయి అందులో ఏమాత్రం తగ్గినా వేరొకరి రక్తం లో ప్లేటి లెట్స్ తీసి ఎక్కించాల్సిన పరిస్థితికి రోగి చేరవచ్చు. మీ అనారోగ్యాన్ని యిట్టె కనిపెట్టే రక్త పరీక్ష,మూత్ర పరీక్షవల్ల ఫలితాలు. పరీక్షలు చేయించండి వ్యాధి ముదరకముందే అనారోగ్యం నుండి తప్పించుకోండి.
read moreకరోనా రోగికి మెకానికల్ వెంటిలేటర్ ఎప్పుడు సూచిస్తారు...
సహజంగా కోవిడ్ తరువాత ముఖ్యంగా రెండవ విడత కోవిడ్ లో చాలా మంది కి పల్స్ పడి పోయి అజ్సిజన్ అందక ప్రాణాలే విడిచిన సంగతి విన్నాము. ఆక్సిజన్ అవసరం అప్పుడు మాత్రమే లోకానికి తెలిసింది. అసలు మెకానికల్ వెంటిలేటర్ ఎలా పని చేస్తుంది.?దాని గురించిన అవగాహన తెలుసుకుని ఉండడం ప్రతిఒక్కరికి అవసరం. ఎవరైతే సహజంగా శ్వాసను తీసుకోలేక ఇబ్బంది పడతారో వారికి అసుపత్రులలో అమ్యులేట రీ సెట్టింగ్ లేదా ఇంటివద్ద వెంటిలేటర్ పెడతారు. సహజంగా మనం విన్నది వెంటిలేటర్ కృత్రిమశ్వాస కోసమే అని అది ఆసుపత్రులలో ఇస్తారని విన్నాం. వైద్య సౌకర్యాలలో వెంటిలేటర్ ఒకటి. మనలో చాలా మంది వాటిని చూడడం కానీ వెంటిలేటర్ పెట్టుకోవాల్సిన అవసరం కానీ మనకు రాలేదు.వెంటిలేటర్ అనేది లైఫ్ సపోర్ట్ మాత్రమే కాదు. జీవితాన్ని మళ్ళీ ఇస్తుంది.జీవితాన్ని కాపాడుతుంది. రోగికి ఎప్పుడు? ఎందుకు?ఎలా అవసరం? అది ఎలా పనిచేస్తుంది? దీనికి రెండు లైఫ్ సేవ్ డివైజెస్ దీని గురించి తెలుసు కోవడం మంచిది వెంటిలేటర్ రోగికి అవసరమా కదా? అది ఎలా పనిచేస్తుంది అన్న విష యంలో సన్నద్ధం కావడం కష్టం. వెంటిలెటర్స్ ఎందుకు అవసరం ?... రోగికి చాలా రకాల ఊపిరి తిత్తుల సమస్యలు ఉండి ఉండవచ్చు. ఊపిరి తిత్తుల కు సంబందించిన రక రకాల కండీషన్స్ ఉంటాయి. సహజంగా పరిస్థితి తీవ్రంగా ఉన్నప్పుడు. క్రిటికల్ గా ఉన్నప్పుడు సహజంగా వ్యక్తి సహజంగా గాలిపీల్చుకోలేనప్పుడు వారు ఆసుపత్రిలో ఉన్నప్పుడు అమ్బ్యులేటరీ పద్ధతి ద్వారా ఇంటివద్ద ఉన్న్సప్పుడు కృత్రిమ శ్వాస అవసరం. దీర్ఘ కాలంగా అనారోగ్యం తో సతమత మౌతూ ఉన్నవారికి లేదా రోగికి శస్త్ర చికిత్స జరిగిన వారికి సర్జరీ నుండి తిరిగి కోలుకుంటున్న వారికి వెంటిలేటర్ అవసరం. వెంటిలేటర్ ఏమిచేస్తుంది ?... ఒక్క మాటలో చెప్పాలంటే ఊపిరి పోయే స్థితిలో ఉన్న వారికి ఊపిరి పోస్తుంది.అది మరో ఊపిరి తిత్తిలా పనిచేస్తుంది. ఎప్పుదతే సహజంగా ఊపిరి తీసుకోవడం లో ఇబ్బంది పడతారో దాన్నివల్ల ఇతర ఆవయవాలకు ఊపిరి అందక ప్రాణాపాయ స్థితికి చేరాల్సివస్తుంది.ఈ సమయంలో రోగి ఊపిరిని నోటినుండి తీసుకుంటాడు ముక్కునుండి గొంతులోకి శ్వాస ను ఊపిరి తిత్తులలోని నాళాలలోకి వస్తుంది. ఎప్పడై తే మల్టిపుల్ ఆర్గాన్ ఫైల్యూర్ అయి అవయవాలు పనిచేయని స్థితికి చేరినప్పుడు శారేరం నుండి కార్బన్ డైయాక్సైడ్ విడుదల చేయదో. శక్తిని తగ్గించి తన ఆరోగ్య సమస్యపై పోరాడెం దుకు శక్తి నిస్తుంది. వెంటిలేటర్ ఎలా పనిచేస్తుంది?... రోగికి వెంటిలేటర్ ద్వారా ఆక్సిజన్ అందిస్తారు. ఆక్సిజన్ ను రెండు పద్దతులలో అందిస్తారు.ఒకటి ఇంవేజివ్,మరొకటి నాన్ ఇన్వేజివ్ పద్దతిలో ఆక్సిజన్ అందిస్తారు. ఇన్వేజివ్ పద్దతిలో రెండు ప్రాసెస్ లు ఉంటాయి. మొదటి పద్దతిలో ఇంట్యుబెషణ్ అంటారు. ఈ పద్దతిలో ట్యూబ్ ను రోగికి నోటిద్వారా ముక్కుద్వారా అందిస్తారు. ట్యూబ్ ను ఒకోసారి ఊపిరి తిత్తులలో అమరుస్తారు. రెండవ పద్దతిలో శస్త్ర చికిత్స పద్ధతి దీనిని ట్రే కియా స్టమి అంటారు. ఈపద్దతిలో ట్యూబ్ ను వెంటిలేటర్ పైప్ కు లేదా ట్రే కియాకు అమరుస్తారు.ట్యూబ్ చివరి భాగాన్ని డివైజ్ కు అమరుస్తారు. వెంటిలేటర్ ద్వారా ఆక్సిజన్ ను గాలిని ఊపిరి తిత్తులకు పంపుతుంది. నాన్ ఇన్వేజివ్ పద్దతిలో బలంగా ఫిట్ చేసిన మాస్క్ ను అమరుస్తారు. కొన్ని సందర్భాలలో అత్యవసర స్థితిలో తీవ్రతను బట్టి లేదా ఊపిరి తీసుకునే పద్దతిని బట్టి వెంటిలేటర్ ఎప్పుడు అవసరమో నిపుణుల సూచన మేరకు అమరుస్తారు. సమస్య ను బట్టి ఆక్సిజన్ శాతాన్ని నియంత్రిస్తూ ఉంటారు. రోగి తాను ఊపిరి పాక్షికంగా తీసుకుంటున్నారా లేక స్వయంగా గాలి తీసుకున్తున్నడా అన్న విషయం నిశితంగా గమనిస్తారు. ఆక్సిజన్, కార్బన్ డయాక్సైడ్ ను ఊపిరి తిత్తులకు పంపుతారు. రోగి స్పందన ఆధారంగా వెంటిలేటర్ ను ఎడ్జెస్ట్ చేస్తూ కృత్రిమ శ్వాసను అందిస్తారు. వెంటిలేటర్ ద్వారా ఒత్తిడి తో కూడిన శ్వాసను అందిస్తారు. దానిద్వారా రోగి ఊపిరితిత్తుల పనితీరు మెరుగు పడవచ్చు.వెంటి లెటర్ పై ఉన్నప్పుడు శ్వాస తీసుకునే శాతం, బి పి,హార్ట్ రేట్ ను మానీటర్ చేస్తారు. అందుకు అనుగుణంగా వెంటిలేటర్ ను సరి చేస్తూ ఉండాలి. కొన్ని ప్రత్యేక పరిస్థితులలో సందర్భాలలో సపోర్ట్ తప్పనిసరి గా అందించాల్సి ఉంటుంది... కొన్ని సందర్భాలలో రేస్పిరేట రీ,నాన్ రేస్పిరేటరీ కండీషన్స్ ఎవరైతే కొన్ని ప్రత్యేక పరిస్థితులలో వెంటి లెటర్ సహకారం అవసరం ఉదాహరణకు రేస్పిరేటరీ ఎలర్జీ,ఆస్తమా, లంగ్ క్యాన్సర్, సి ఓ పి డి, అక్యూట్ రి నాల్ ఫైల్యూర్, ఇన్ఫెక్షన్,నిమోనియా, బ్రోన్కైటిస్, వంటి సమస్యలతో తీవ్ర ఇబ్బందులు ఎదుర్కుంటు న్నారో లేదా ఊపిరి తిత్తులలో ఉండే లక్షణాలు.ఒఊరి తిత్తుల లోని కండరాలు బలహీనంగా ఉన్నాయో డయాఫ్రం,మస్క్యులర్ డిస్త్రఫీ, ఉన్న వారికి వెంటిలేటర్ అవసరం.ముఖ్యంగా అప్పుడే పుట్టిన బిడ్డల కు వెంటిలేటర్ సపోర్ట్ అవసరం వారి కోసం ప్రత్యేకంగా వెంటిలెటర్స్ తయారు చేయాల్సి ఉంటుంది. మందులు అధికంగా తీసుకున్న వారు. రేస్పిరెటరీ, దిఒరెశన్ ఉన్నవారికి వెంటిలేటర్ అవసరం.
read moreఆంజియోమా గురించి తెలుసా ?
ప్రతి ఒక్కరికీ వైద్య పరిభాష ను అర్ధం చేసుకోవడం కష్టం. అసలు మనకు వైద్యపరిభాష అర్ధంకాక జుట్టు పీక్కోవాల్సిందే. అలా చెప్పుకోవాల్సిన మరో అనారోగ్యసమస్యలలో ఒకటి అన్గియోమాస్అంటే ఎర్రటి కురుపులు అనేది ఒక హానికారకం కానీ కణిత గా చెప్పవచ్చు. ఇది నాళాలలో మాత్రమే వస్తుంది. ఇలాంటి ఎర్రటి కురుపులు లేదా కణితలు శరీరంపై ఎక్కడన్నా గుర్తించవచ్చు. ఆంజియోమా లక్షణాలు... కొన్ని వేరు వేరు రకాల ఎర్రటి కురుపులు ఉంటాయి ఆన్గియో మాస్ ఉంటాయి అందులో ఒకడి సాలీడు రకంకురుపులు అన్గియో మాస్, చెర్రీ రకం కురుపులు ఆంజియోమా వివరణ... సెనిల్ రకం కురుపులు ఆంజియోమా హానికారకం కాని కణితలు రక్త నాళాలలో ఉంటాయి.దీనిని హెమన్గియో మాస్, హానికారకం కానీ కణితలు లింఫ్ నాళా లలో వస్తాయి.దీనినే లింఫ్ ఆంజియోమా పోర్ట్ వైన్ స్టైన్స్ లేదా పుట్టినప్పుడు వచ్చిన గుర్తులు హేమాన్గియో మాస్ లేదా కేశ నాళిక లలో ఉంటాయి. ఆంజియోమా కు చికిత్స ... ఆంజియోమా ను తొలగించేందుకు స్ప్రే లిక్విడ్ ను, లేదా లిక్విడ్ నైట్రోజన్ ను చర్మం పై రాస్తారు.ఎక్కడైతే చర్మం బిగుసుకు పోయి ఉంటుందో ఒక్కోసారి మళ్ళీ మళ్ళీ అన్గియో మాస్ మళ్ళీ మళ్ళీ వచ్చే అవకాశం ఉంది.అన్గియో మాస ను కాస్మెటిక్ కారణంగా చికిత్స చేస్తారు.
read moreఅకోండ్రోప్లాసియా...
కొన్ని కొన్ని పేర్లు మ్సామాన్యులకు అర్ధం కాదు. మరీ వైద్య పరిభాష అర్ధం కాదు. అందులో భాగంగా అకోండ్రోప్లాసియా ఒకటి వివరణ... అకోండ్రోప్లాసియా అనేది ఒక జన్యు పరమైన రుగ్మత . ఇందులో ఎముకల లో పెరుగుదల లోపం కారణం కావచ్చు. లేదా జన్యుపరంగా వచ్చే మార్పులు కారణం కావచ్చని అంచనా దీనికారణంగా వచ్చిన స్థితిని మరగుజ్జు తత్వంగా పేర్కొన్నారు.అచోన్ ద్రోప్లసియా వల్ల కీళ్లలో వికృత రూపం వస్తుంది. అదీకాక కండరాలు బలహీనంగా ఉండడం లేదా ఎదగక పోవడం వల్ల ఒక్కోసర్రి మరించే అవకాశాలు ఉన్నాయని అంటున్నారు.చాలామంది నిద్రావస్థలో ఉన్నప్పుడే మరణించారు దీనికిగల కారణాలలో వెన్నుపూస పై భాగం ఒత్తుకు పొయి ఉండవచ్చని దీనికి మరోకారణం గా పుర్రె లో అసాధారణ గా ఫోర్మేన్ మాగ్నమ్ లలో ఉండడమే అనిపెర్కొన్నారు.ఇది వెన్నెముక కు అనుసంధానం చెయబడి పనిచేస్తూ ఉంటుంది.అలాగే వెన్నుపూస మరియు మెడ భాగానికి కలపబడి ఉంటుంది. అకోండ్రోప్లాసియా లక్షణాలు... శరీరంలో ఉన్న వివిదరకాల అవకరాలు వల్ల పెద్దలలో సహజంగా మొత్తం మీద ఎత్తు నాలుగు అడుగులే. అచోస్ ద్రోప్లసియా ఉన్నవారిలో పొట్టి కాళ్ళు చేతులు,వారి మొండెం సైజు మామూలుగానే ఉంటుంది.చేతి పై భాగం, చేతుల కన్నా తొడలు చాలా పొట్టిగా ఉంటాయి.వారి ముక్కు సైతం చాలా బల్లపరుపుగా ఎత్తుపల్లా లుగా ఉంటాయి. ఈ వ్యాధితో బాధపడే వారి చేతి వెళ్ళు పొట్టిగా ఉంటాయి మూడు నాల్గవ వేలి మధ్య ఒక త్రిశూలం ఆకారం లో ఉంటుంది అకోండ్రోప్లాసియా కు చికిత్స... ఈ అచోన్ ద్రో ప్లేసియా సమస్యకు ప్రత్యేకమైన చికిత్స అంటూ లేదు. శారీరకంగా వచ్చే పెరుగుదల లేదా అవలక్షణాలను ముఖ్యంగా .వైకాల్యాలను శస్త్ర చికిత్స ద్వారా చేయవచ్చు.
read moreచీము ప్రమాదకరమా ?
శరీరంలో వచ్చే వివిదరకాల గాయాల వల్ల,చర్మం పై వచ్చే వివిదరకాల గాయాల వల్ల చీము పోరలోకి చేరుతుంది. ఆరకంగా మైక్రూర్ ఒర్గానిజమ్స్ పై దండయాత్ర చేస్తుంది.చర్మం పై వచ్చే చీము తరచుగా స్టే ఫి లోకో చసుస్ ఔరెఉస్ బాక్ట్రియా చర్మం లో గాయాలకు కారణం అవుతుంది. అయితే చీమును నివారించవచ్చు శరీరంలో గాయాలను తగ్గించడం ద్వారా లేదా దీర్ఘ కాలం అనారోగ్యం తో బాధపడుతూ మంచం పైనే జీవితాన్ని వెళ్ళ దీస్తున్న వారిలో బెడ్ సోర్స్ వచ్చే పుండు. వల్ల చీముజేరుతుంది. కాగా డయాబెటీస్ తో గా యమై తరువాత చీముచేరితే ఇన్ఫెక్షన్ ను తగ్గించడం అసాధ్యం. డయాబెటిక్ ఫుట్ వల్ల వేలిని కాలి లో వస్తున్న చీమును నివారించడం అసాధ్యం ఒక్కోసారి కాలి కింది భాగం లో లేదా పై భాగం తొలగించాక్సి రావడం కేవలం చీమువల్లె అనినిపునులు పేర్కొన్నారు. కాగా చీము ఒక్కోసారి తెల్లగా ఉండడం, పసుపు రంగులోకి మారడం వంటివి జరగవచ్చు. చీముజేరిన వ్యక్తి ఇబ్బందులు పడుతుంటే సమీపంలోని వైద్యునివద్ద చికిత్స చేసుకోవాలి.లేదా చీము ప్రాణాంతకం కావచ్చు. చీము లక్షణాలు... చీము శరీరంలో చుట్టుపక్కల ఉన్న కణ జలాన్ని ఇబ్బంది పెడుతుంది.ఇంఫ్లామేషణ్ కారణంగా సరిగా పనిచేయక పోవచ్చు. మైక్రూ ఒర్గానిజమ్స్ లో చీము విస్తరిస్తుంది. దీనివల్ల పెద్ద శరీరంలోని ఇతర భాగాలోకి చీముచేరవచ్చు. చీము నిర్ధారణకు పరీక్ష... చీముకు నిర్ధారణకు ప్రత్యేకమైన నిర్ధారణ పరీక్షలేదు. శరీరంలోని గాయాల ను గుర్తించడం ద్వారా అందులో ఇన్ఫెక్షన్ కు గల కారణాలను గుర్తించవచ్చు. చీముకు చికిత్స... చీమును నివారించేందుకు యాంటి బాయిటిక్స్ చికిత్స చేస్తారు.ఒక్కోసారి చీము ఎక్కువగా ఉండే పక్షంలో దానిని తొలగించేందుకు ప్రయత్నం చేస్తారు.
read moreగౌట్ ఆర్థరైటిస్ వస్తే??
అసలు గౌటి ఆర్తరైటిస్ అంటే ఏమిటి ? గౌట్ ఈ మద్య కాలం లో తరచుగా వైద్య రంగం లో వస్తున్న ఒక డిజార్దర్. మానవులలో దీని చరిత్రను చూసినప్పుడు శరీరంలో వివిదరకాల అనారోగ్య సమస్యలు చుట్టుముడతాయి. శరీరంలో యూరిక్ యాసిడ్ అతిగా తీసుకున్న కారణంగా ఈ సమస్య రావచ్చు. ముఖ్యంగా ఎవరికైతే చాక్లెట్లు,సముద్రపు ఆహారం, ఎర్రటి వైన్, వంటివి తీసుకోవడం ద్వారా శరీరాన్ని నిర్వీర్యం చేస్తుంది. అది కీళ్ళ మధ్యలో,రాళ్ళలా గట్టిగా క్రిస్టల్స్ గా మారి,ముఖ్యంగా అరికాళ్ళ లోని జాయింట్స్ లో, యాంకిల్స్, చేతులు,ఎల్బోస్, ముంజేతుల లో, ఇంఫ్లామేషణ్ తో గౌట్ వస్తుంది. దీనినే గౌట్ ఆర్తరైటీస్ అని అంటారు. ఆర్త్ రైటీస్ తీవ్రత అధికంగా ఉంటుంది. యూరిక్ యాసిడ్ వల్ల కిడ్నీ లలో రాళ్ళు పేరుకు పోవచ్చు. దీనివల్ల కిడ్నీలో అడ్డుగా మారవచ్చు. దీనికారణంగా కిడ్నీ యే పూర్తిగా పడిపోవచ్చు. లేదా కిడ్నీ ఫైల్యూర్ అయ్యే అవకాశం ఉందని నిపుణులు పేర్కొన్నారు. గౌట్ బారిన ఎవరు పడవచ్చు?... స్త్రీ,పురుషులు గౌట్ బారిన పడడం సహజం. 5౦ సంవత్సరాల తరువాత ప్రతి ఒక్కరు ఎప్పుడో ఒకప్పుడు గౌట్ బారిన పడడం సహజం ఒకవేళ తల్లి తండ్రులకు గౌట్ వస్తే కుటుంబ సభ్యులకు వచ్చే అవకాశం లేకపోలేదని నిపుణులు నిర్ధారించారు.అంటే సహజంగా దీనిని అంటే వంశ పారం పర్యంగా వచ్చే అవకాశం తోసిపుచ్చలేమని అంటున్నారు వైద్యులు. గౌట్ వల్ల ఎలాంటి సమస్యలు వస్తాయి?... గౌట్ ఉన్నవారిలో ఊబకాయం, అమాంతం బరువు పెరగడం,ఆధునిక జీవితం లో అతిగా మందు సేవించడం. హై బిపి, కిడ్నీ సరిగా పనిచేయక పోవడం. చికిత్సలో భాగంగా కొన్నిరకాల వాటర్ పిల్ల్స్ తక్కువ స్థాయి హార్మోన్ల వల్ల కూడా గౌట్ వచ్చే అవకాశం ఉందని పేర్కొన్నారు. గౌట్ లక్షణాలు ఏమిటి?... శరీరం లోని కాలు కింది భాగం పైన ఉండే జాయింట్లు,అకింది భాగం లోఉన్న యాంకిల్, జాయింట్ లలో గౌట్ వస్తుంది. ఏది ఏమైనా ఇతర జాయింట్ల లో గౌట్ వచ్చే అవకాశం ఉంది అని నిపుణులు హెచ్చరిస్తున్నారు.కాళ్ళలో కీళ్ళు,పాదాలు,ముంజేతులు,యాంకిల్ జాయింట్స్,ఎల్బోస్, వెళ్ళు లలోను గౌట్ వచ్చే అవకాశం ఉంది. గౌట్ వచ్చిన రోగులు తీవ్ర మైన నొప్పుల తో బాధపడుతూ ఉంటారు. కళ్ళలో జాయింట్లలో వాపులు,ఎర్రగా మారడం.ఒక్కోసారి చిన్నగా దుప్పటి తగిలినా తీవ్రమైన నొప్పులు వస్తాయి. కాళ్ళలో వాపులు నొప్పులు కొన్ని ఘంటల పాటు కాకుండా కొన్ని రోజుల పాటు ఉంటాయి. గౌట్ ఇంఫ్లా మేషన్ వల్ల వారం రోజులు గా ఉంటుంది. దురదృష్ట వసాతూ గౌట్ మళ్ళీ మళ్ళీ వస్తూ ఉంటుంది. పెద్దపాడానికి గౌట్ ... పెద్దపాదాల వద్ద ఉన్న జాయింట్లలో గౌట్ సహజంగా వస్తుంది.ఇతర జాయింట్లలో అంటే కింది యాంకిల్స్, మోకాళ్ళ లో ని జాయింట్స్ , చేతి వెళ్ళు, ఎల్బోస్ లో కూడా గౌట్ వస్తుంది. ఎక్కడైతే ఇంఫ్లామేషణ్ ఉన్న ప్రాంతంలో గౌట్ ను గుర్తించవచ్చు.నొప్పి తీవ్రత పెద్దగాలేని ప్రాంతాలలో కూడా గౌట్ వస్తుంది. ఆర్తో సెంటసిస్ పద్ధతి ద్వారా గౌట్లో ఉండే ఫ్లూయిడ్ ను గుర్తిస్తారు. యూరిక్ యాసిడ్ క్రిస్టల్స్ ను నిశితంగా పరిశీలిస్తారు. యూరిక్ ఎకోలసిస్ ద్వారా ఇతర సమస్యలను గుర్తించవచ్చు. బ్యాక్టీరియా ఉందా లేదా బ్యాక్తీరియాలో ఎలాంటి ఇన్ఫెక్షన్ ఉందా ? లేదా ? అన్న విషయాన్ని గమనించవచ్చు. గౌట్ నివారణ చర్యలు... గౌట్ నివారణకు అధికంగా నీరు తాగాలి. కిడ్నీలలో, రాళ్ళు చేరకుండా జాగ్రత్త పడాలి.కిడ్నీలలో యూరిక్ యాసిడ్ క్రిస్టల్స్ వస్తే యూరిక్ యాసిడ్ వల్లకిద్నీలే పనిచేయకుండా పోవచ్చు.లేదా వైద్య పరిభాషలో హైపర్,యురి నేమియా రావచ్చు. గౌట్ సమస్యకు ఎలాంటి ఆహారం తీసుకోవాలి ... షెల్ ఫిష్, ఆర్గాన్ మీట్, లివర్,కిడ్నీ బ్రెయిన్ స్వీట్ బ్రెడ్ తీసుకోవడం ద్వారా బరువు తగ్గించుకునే ప్రయాత్నం చేయవచ్చు. ఆహారం లో ఫ్యాట్ లేని ఆహారం తీసుకోవడం, శరీర వ్యాయామం తీసుకోవాలి. ఇక చికిత్స విధానానికి వస్తే... స్తేరాయిడ్ లేని మందులు, యాంటి ఇంఫ్లామేటరీ, కొల క్రైసిస్ కార్తిక్ స్టేరోయి డ్స్ వాడవచ్చు అది మీసమీపంలోని నిపుణులైన వైద్యుల సమక్షంలో మందులు వాడాల్సి ఉంటుంది.
read moreమోటార్ న్యూరాన్ తెరఫి...
మెదడు లో ఉండే మొట్రాన్ తెరఫి తో ఏ ఎల్ ఎస్ కు చికిత్స చేయవచ్చు. మెదడులో ఉండే మొట్రాన్ న్యురాన్స్ స్పైన్ సమస్య కాదు అంటున్నారు నిపుణులు. మెదడులో ఉండే మొట్రాన్ న్యురాన్స్ లో వచ్చే సమస్యలకు మెదడు మాత్రమే లక్ష్యం గా ఏ ఎల్ ఎస్ చికిత్స కు అంటే మాయో ట్రాఫిక్ లేటరల్ స్క్లేరో సిస్ కు చికిత్స ను శాస్త్రజ్ఞులు కనుగొన్నారు. దీర్ఘ కాలంగా వ్యాధి మాత్రమే వస్తుందని మోటార్ న్యురాన్ తెరఫి ద్వారా స్పైన్ లక్ష్యంగా కీలక చికిత్స చేయవచ్చు. నూతన పరిశోదన ప్రకారం మెదడులో డీజనరేషన్ కావడం వల్ల ఏ ఎల్ ఎస్ ఎమ్యు ట్రాఫిక్ లేడరల్ స్క్లిరోసిస్ గా వైద్య పరిభాషలో పిలుస్తారు. ఈ వ్యాధికి సంబంధించి వార్నింగ్ సంకేతాలు మనకు చెపుతుందని వ్యాధి వచ్చినావారిలో డిఫ్ఫెక్ట్స్ సత్వరం గుర్తించాలని డీ జన రేషన్ ఆఫ్ బ్రెయిన్ మోటార్ న్యురాన్స్ స్పైనల్ మోటార్ న్యురా అనుబంద ఉత్పత్తి కాదనిస్పైనల్ మోటార్ న్యురాన్ డీజనరేషన్ అన్న అంశం స్పైనల్ మోటార్ గా పేర్కొన్నారు అప్పటి ఆలోచన గా పేర్కొన్నారు. మెదడు బ్రెయిన్ లక్ష్యంగా ఏ ఎల్ ఎస్ చికిత్స నార్త్ వేస్టేన్ లోని సైన్తిస్ట్లులు ఈ విధానాన్ని కనుగొన్నారు.గతం లో చాలా కాలంగా ఉన్న నమ్మకం ఏమిటి అంటే వ్యాధి స్పైన్ లో వస్తుంది అని. నార్త్ వేస్టన్ పరిశోదన ప్రక్జారం బ్రెయిన్ మోటార్ న్యురాన్స్ డీ జనరేట్ కావడం వల్లే మెదడులోని నరాలు కాళ్ళను నియంత్రిస్తాయి. అయితే ఇది స్పైనల్ మొత్రాల్ న్యురాన్ డీజనరేషన్ అని గతంలో భావించేవారు. మెదడులో ఉన్న డీజనరేషన్ ముందుగా గుర్తిస్తే ఏ ఎల్ ఎస్ గుర్తించ వచ్చు. అంటున్నారు నిపుణులు.
read moreడీప్ బ్రెయిన్ స్టిమ్యులేషన్ థెరపీ...
ఎన్ ఐ హెచ్ ఎల్ నేషనల్ ఇన్స్టిట్యుట్ ఆఫ్ హెల్త్ న్యురో లాజికల్ డిజార్డర్స్ స్ట్రోక్ అన్న అంశం చాలా పెద్దది. ఇటీవలే న్యూరో డిజార్డర్స్ పై పరిశోదనలు 1౦౦౦ ఘంటలు పైగా రోగుల పై బ్రెయిన్ రికార్డింగ్ ను నిర్వహించారు. వారి ఓ సి డి క్లినిక్ లో,ఇంటి వద్ద నిర్వహించారు. ఈ సమాచారం ఇది తొలి అడుగుగా శాస్త్రజ్ఞులు పేర్కొన్నారు. డీప్ బ్రెయిన్ స్టిమ్యులేషన్ తో న్యూరో సైక్రియాటిక్ డిజార్దర్ సమస్యలకు చికిత్స చేయవచ్చని శాస్త్రజ్ఞులు పేర్కొన్నారు. ఒక చిన్న పరిశోదనలో పరిశోధకులు నేషనల్ ఇన్స్టిట్యుట్ ఆఫ్ హెల్త్ ఆర్ధిక సహాయం తో 1౦౦౦ ఘంటల కు పైగా ప్రయోగాత్మకంగా బ్రెయిన్ రికార్డింగ్ ను ఇంటి వద్ద క్లినిక్ లో నిర్వహించారు. ఈ సమాచారం డాటా డీప్ బ్రెయిన్ స్టిమ్యులేషన్ చికిత్స ద్వారా న్యూరో సైక్రియాటిక్ డిజార్డర్స్ ను నివారించడం లో రోగులకు పునర్జీవితం ఇచ్చినట్లే అని అంటున్నారు వైద్యులు. పార్కిన్సన్స్ ట్రాక్షన్ ద్వారా సైక్రియాటిక్ లక్షణాలకు అ ప్సేసివ్ కంపల్సివ్ డిజార్దర్ అంశం పై న్యూరో మెడిసిన్ లో ప్రచురించారు. నేషనల్ న్యూరో డిజార్డర్స్ న్యురోలజికల్ డిజార్డర్స్ స్ట్రోక్ సహకారం తో చేసిన బ్రెయిన్ రీసెర్చ్ ఎల్విన్సింగ్ ఇన్నోవేటివ్ న్యూరో టెక్నాలజీస్ అధునాతన న్యూరో టెక్నాలజీ తో చేసిన పరిశోదన లు చేపట్టారు. ఇంటివద్ద క్లినిక్ లో బ్రెయిన్ రికార్డింగ్ ను పరిశోదన ద్వారా అడ్సిసివ్కంపల్సివ్ డిజార్దర్ ఎన్ ఐ హెచ్ బ్రెయిన్ ఇనిషియేటివ్ గురించి డాక్టర్ జిన్ జే నాగాయి మాట్లాడుతూ బ్రెయిన్ ఇనిషియేటివ్ ద్వారా తీవ్ర ప్రభావం ఎలా ఉంటుందో నిరూపించే ప్రయాత్నం ప్రయత్నం చేసారు. బ్రెయిన్ యునివర్సిటీ కి చెందిన ప్రొఫెసర్ వేడిన్ బయో మెడికల్ ఇంజనీర్ అసోసియేటెడ్ ప్రొఫెసర్ జోర్డాన్ డీప్ బ్రెయిన్ స్తిమ్యు లేషన్ తెరఫీ పరిశోదనకు నాయాకత్వం వాహించారు. ఈ బృందంలో రోడే ఐలాండ్ వే ఎన్ గుడ్ మాన్ ఇల్రేనే ఎల్వుడ్ అధ్యక్షులు సైక్రియాట్రీ బాయిల్ కాలేజ్ ఆఫ్ మెడిసిన్ హూస్టన్ బ్రెయిన్ రికార్డింగ్ ను ముగ్గురు రోగుల వద్ద సమీకరించారు. డీప్ బ్రెయిన్ స్టిమ్యులేషన్ కు ఓ సిడి చికిత్స తీసుకున్నారు. ఈ రికార్డింగ్ ను టెలి తెరఫీ సెషన్ ద్వారా సహజంగా వారు నిత్యం చేసే వ్యవహార శైలి,పై బ్రెయిన్ రికార్డింగ్ నిర్వహించారు. ఈ డాటా బ్రెయిన్ న్యురల్ సిగ్నేచర్స్,ప్రవర్తన,లక్షణాలు గుర్తించడం ద్వారా ప్రత్యేకమైన డి బి ఎస్ చికిత్సలో మార్పులు చేర్పులు చేయవచ్చు. రికార్డులు ప్రత్యేకంగా ముందడుగు రోగులు వారి వాతా వరణం నిత్యజీవితా ల లో ఎలాంటి ప్రభావం చూపుతుంది. ఓ సి డి న్యూరో సైక్రియాటిక్ డిజార్దర్స్ కు చికిత్స చేయడం అన్నదిపెద్ద సవాలుతో కూడుకున్నది. వారి లక్షణాలు ఒక్కో సారి స్థిరంగా ఉండవచ్చు. లేదా ఉండక పోవచ్చు.మార్పు వస్తూ ఉంటుంది. మోటార్ డిజార్దర్స్ లో ముఖ్యంగా పార్కిన్సన్స్ ఓ బి ఎస్ తో పాటే పెరుగుతుంది. ఓ సి డి లక్షణాల లో భాగం గా అప్పుడప్పుడు వచ్చి పోతూ ఉంటుంది.ఆ వ్యక్తి నివసించే వాతావరణం లో మార్పులు వస్తూ ఉంటాయి. ఒక్కోసారి వాతావరణ ప్రభ్హవం వల్ల కూడా మార్పులు సంభవిస్తూ ప్రభావితం అయ్యే అవకశాలు ఉన్నాయని నిపుణులు భావిస్తున్నారు. ఓ సి డి కి ప్రస్తుతం ఓ బి ఎస్ తెరఫితో ఎలాక్రోర్స్ ఇంప్లాంట్ చేస్తారు. దీనిద్వారా స్టిమ్యులేషన్ చేసి క్లినిక్ లోనే ఉత్తమమైన స్టిమ్యులేషన్ విధానాన్ని అవలంబిస్తామని డాక్టర్ బోర్దన్ అన్నారు. అయితే లక్షణాలు రావడానికి కారణాలు చాలానే ఉండవచ్చుక్లినిషియన్ ఓబీ ఎస్ పద్ధతి ద్వారా రోగికి క్లినిక్ లోనే ఉంటాడు. కొన్ని కొన్ని సందర్భాలాలో వారి వారి అవసరాలను మార్చాల్సి ఉంటుంది. వారు చికిత్స తరువాత క్లినిక్ నుండి వెళ్ళిన తరువాత మార్చుకోవాలి. మరో సవాలు ఏమిటి అంటే బయో మార్కర్స్ వల్ల మెదడు పనిచేసే విధానం లో చాలా మార్పులు ఉంటాయి. దీనికి అదనం గా ఓ సి డి లక్షణాలు తోడైతే న్యూరో సైక్రియాట్రిక్ డిజార్దర్ చికిత్స ప్రభావమైతే కొన్ని కొన్ని సార్లు చికిత్స వారాలు,లేదా నేలలు, చికిత్సకు సమయం పట్టవచ్చు అంటున్నారు పరిశోధకులు. అంటే దాని అర్ధం క్లినిషి యన్స్ ప్రోగ్రామింగ్ పై ఆధార పడిఉంటుంది.ఓబీ ఎస్ సిస్టం అన్నది రెండవ అంశం మాత్రమే చికిత్స తరువాత రోగులు చాలా ఆనందంగా సంతోషంగా ఉంటారు. లేదా ఎక్కువగా మాట్లాడే అవకాశం ఉంది. ఓబీ ఎస్ పోజిటివ్ రెస్పాన్స్ రావచ్చు... స్టిమ్యులేషన్ ప్రభావం వల్ల మనం స్టిమ్యులేషన్ సరైన పరిదిలో సరిగ్గా చేస్తున్నామా లేదా అన్నది మనకి తెలుస్తుంది.స్టిమ్యు లేషన్ ఐ డి యా ట్యూన్ చేసామా లేదా అన్నది మని డాక్టర్ గుడ్ మ్యాన్ అన్నారు. పరిశిదకులు వారి పరిశోదనలో ఈ సవాళ్ళను సాంకేతికతను వినియోగించి ఎలా ఎదుర్కోవచ్చో తెలుస్తుంది. గతంలో పర్కిన్సన్స్ బ్రెయిన్ పై ఏమైనా ప్రయోగించారా లేదా అన్నది వివిధ రకాల పరేక్షల ద్వారా నిర్ధారిస్తారు. ప్రస్తుతం చేసిన పరిశోదనలో చేసిన బ్రెయిన్ రికార్డింగ్స్ ను ఎలాక్రాడ్స్ కారణంగా ఓబీ ఎస్ తెరఫీ ఇ ఇ జి సమయం ఆధారంగా మానసికంగా రికార్డు చేసినప్పుడు ముఖం లో మార్పులు వస్తూ ఉంటాయి. లక్షణాలను బట్టి ఎలా స్పందిస్తారు.అన్నది గమనించవచ్చు. టెలి తెరఫి సర్క్యుట్స్ లేదా వారు చెప్పిన లక్షణాల ను బట్టి ప్రతిరోజూ తమ జీవన శైలి పై ఎలాంటి ప్రభావం చూపుతుంది ఇంట్లో వ్యవహార శైలి ఎలా ఉంటుందో తెలుస్తుంది. డైవర్స్ డాటా ఆధారంగా పరిశోధకులు రోగుల,వ్యక్తుల న్యూరో సిగ్నేచర్స్ ను బట్టి ఓ సి డి బ్రెయిన్ యాక్టివిటి లో మార్పులు ఆయా సమయాలను బట్టి క్లినికల్ స్కోర్స్ ఒసిడి లక్షణాలను బట్టి ముందుకు సాగుతామని నిపుణులు అంటున్నారు. వారిలో వచ్చే రెస్పాన్స్ ఆధారంగా స్టిమ్యులేషన్ పై దృష్టి పెడతారు వారికి బయో మార్కర్స్ లక్షణాలను బట్టి పనిచేస్తాయా లేదా అన్నది కూడా నిర్ధారించుకోవాలి. .
read moreమరో ప్యాండమిక్ వస్తే??
ప్రపంచ దేశాలు మరో ప్యాండమిక్ కు సిద్ధం గా ఉన్నట్ల లేనట్ల? ప్యాండమిక్ అంటే నే భయం ఎక్కడనుంచి ఎలా వస్తుందో దాని ప్రభావం ఎలా ఉంటుందో ఊహించుకుంటేనే ఒళ్ళు జలదరిస్తుంది. అసలు మొదటి సారి వచ్చిన ప్యాండమిక్ విషయంలో పూర్ర్హిగా అవగాహనా లేమి కనపడింది. కాగా రెండవ విడత ప్యాండమిక్ లో నూ అదే పనితీరు.అటు ప్రజా ఆరోగ్యం, చికిత్స పద్దతులు. ప్రజా ఆరోగ్యానికి అవసరమైన మౌలిక సదుపాయాల కల్పనలో తీవ్ర నిర్లక్ష్యం తో మరిన్ని ప్రాణాలు కోల్పోయారు. మేము అంతా తర్వాత వచ్చే ప్యాండమిక్ వస్తుందన్న నేపధ్యం లో ఒకరకమైన ప్రకటనల నేపధ్యం లో కోవిడ్ ను నియంత్రించేందుకు తయారు చేసిన వ్యాక్సిన్ల ప్రభావం తక్కువే,తామర తుంపరగా పెరిగి పోతున్న కోవిడ్ వేరియంట్లను ఎదుర్కునే శక్తి వ్యాక్సిన్లకు ఉందా? అన్నది. సందేహంగా మారింది. వైరస్ అనేది ల్యాబ్ లలో దాని ద్వారా ముఖ్యంగా పిల్లలకు మీజిల్స్ తట్టు వంటి సమస్యలు, పోలియో వంటి వ్యా దుల బారిన పడకుండా వ్యాక్సిన్ లు కనిపెట్టారు. ముఖ్యంగా కుక్కకాటుకు కూడా వ్యాక్సిన్ కనిపెట్టినా వాటి ప్రభావం ఏమాత్రం ఉంది అన్నది మరోప్రశ్న?. ప్రపంచం కోరోనాను ఎదుర్కునేందుకు సన్నద్ధంగాలేకపోవడం వల్లే తీవ్రత ప్రభావం ఎక్కువ గా ఉందని దాని ప్రభావం సమర్ధంగా ఎదుర్కోవడం లో విఫలమయ్యా మా? లేదా మరో ప్యాండమిక్ ను ఎదుర్కోడానికి సిద్ధ మౌతున్నమా ? అన్నది ప్రశ్న ? చాలా దేశాలు కోరోనా నిర్మూలనకు సరైన చర్యలు చ్గేపట్టడం లేదన్నది వాస్తవం? అసలు ముందు ముందు భవిష్యత్తు ఎలాఉంటుంది అన్న అంశం పై ఒక రిపోర్ట్... జి హెచ్ ఎస్ గ్లోబల్ హెల్త్ సేక్ర్యు రీటి ఇండెక్స్ చేసిన సంనద్దత ఆయా సందర్భాలలో ఆరోగ్యం అత్యవసర సమయం లో ఎలాంటి సమస్యలు వస్తాయి. న్యూక్లియర్ ద్వారా వచ్చే సమస్యలు ఆర్ధిక పరిస్థితుల ప్రభావం అంశం పై జాన్ హాప్కిన్స్ సెంటర్ ఫర్ హెల్త్ సెక్యూరిటీ బ్లూమింగ్ స్కూల్ ఆఫ్ పబ్లిక్ హెల్త్ కొన్ని అంశాలను వెల్లడించింది. 2౦21 జి హెచ్ ఎస్ ఇండెక్స్ సంస్థ వెల్లడించిన అంశాల ప్రకారం... అన్నిదేశాలలో అత్యవసర సమయంలో వారి వద్ద ఉన్న శక్తి సామర్ధ్యాలు స్పందించినప్పుడు వారిలో ఉండే సత్త కోవిడ్19 పై ప్రభావ వంతం గా తీవ్రంగా స్పందించడం లో వారిలో ఉండే సత్త కోవిడ్ 19 పై ప్రభావ వంతంగా తీవ్రంగా స్పందించడం ఎలా ఉండాలి అన్న అంశం పై పూర్తిగా అవగాహన లేకపోవడం పరిస్థితికి అనుగుణంగా సిద్ధంగా లేకపోవడం చూస్తే ఆర్ధికంగా,ప్యాండమిక్ వల్ల ప్రమాదం దేశాలలో 1౦౦ కి ౩8.9% మాత్రం మార్కులు సాధించాయి. 2౦19 నాటి కన్నా ఏ మాత్రం మార్పులేదని నిపుణుల అంచనా మొత్తం మీద యు.ఎస్ లో 76% లోపే ఉందని పేర్కొన్నారు. ప్రజా ఆరోగ్యానికి సంబందించిన ఉత్పత్తుల తయారీ,నివారణ, అత్యవసర సమయంలో వచ్చే పెతజన్స్ వంటి అంశం లో ప్రపంచ వ్యాప్తంగా చాలా తక్కువ ఇక అత్యవసర సమయంలో పెతోజన్స్ నివారణలో 1౦౦ కి 28. 4%గా ఉన్నట్లు గుర్తించారు. 11౩ దేశాలలో పెద్దగా అప్రమత్తంగా లేరని. వ్యాధి వ్యాప్తి జంతువులనుంచి మనుషులకు సంక్రమించింది. ౩ సంవత్సరాల కాలం లో 195 దేశాలలో 155 దేశాలు సర్వేలో ప్యాం డమిక్ కు సన్నద్ధం లేదని.ఎపిడమిక్ లో 7౦ % క్లినిక్లు ఆసుపత్రులు కమ్యూనిటి హెల్త్ సెంటర్స్ లో ను సన్నద్ధం గా ఉన్నట్లు కనబడడం లేదు. నేడు నాయకులకి ఒక అవకాశం ఉంది. డాక్టర్ జేన్నిఫార్ నుజ్జో సీనియర్ స్కాల్లర్ జాన్స్ హాప్కిన్స్ సెంటర్ సెక్యురిటీ బాల్టి మోర్ మాట్లాడుతూ దేదికేటెడ్ గా పెట్టుబడులు కొనసాగించాలని ఎవరి శక్తి కొలది వారు కోవిడ్ 19 పై స్పందించాల్సిన అవసరం ఉదని అన్నారు. దీర్ఘకాలిక అంశంగా పరిగణించి దశాబ్దాలు సాగించవచ్చు ఒకవేళ మనం ఏ మాత్రం నిర్లక్ష్యం చేసినా ప్రపంచం స్మసనంగా మారుతుంది. భవిష్యత్తులో మరిన్ని సవాళ్లు ఎదుర్కోక తప్పదు.ఆత్మ విశ్వాసం కోల్పోవడం అంటే ప్రజా ఆరోగ్యం పట్ల వ్యాధినిర్ధారణ నిరోధం విషయంలో అంతా మాస్క్ ఇంటి వద్దే ఉండడం,వ్యాక్సినేషన్, నియంత్రణ,ప్రోటో కాల్స్ వంటివి మన ముందున్న సవాళ్ళు. రెండు సంవత్సరాల పాటు యు ఎస్ రాజాకీయ నాయకులు ఆరోగ్య అధికారుల లక్ష్యాలు,ఉద్దేశాలను ప్రశ్నించారు. ఈ ఆంశాల పైన చర్చలు జరిపారు. ప్రజా ఆరోగ్యం సంరక్షించేందుకు చేపట్టిన చర్యలు ప్రజలు అంగీకరించారా లేదా? తక్కువధరకే వైద్య సేవలు అందించడం సాధ్యమా? వైద్యసేవల పై పరిమితులు నియంత్రణ,ముఖ్యంగా రోగులకు మెరుగైన సేవలు అందించడానికి వీలైన బెడ్లు,మౌలిక సదుపాయాల కల్పనకు పెట్టు బడులు ప్రోత్సాహం వైద్యానికి ప్రభుత్వాలు,ఆసుపత్రులు కొను గోలు చేసే పరికరాల దిగుమతుల విషయంలో ఇచ్చిపుచ్చుకునే ధోరణి ఉందాలేదా అన్నది మరో ప్రశ్న. ఇలా అసలు కోవిడ్ కు వేరియంట్లకు ఎలాంటి చికిత్స చేయాలి అందుకు సంబందించిన దిశా నిర్దేశం చేయడం లో ప్రజా ఆరోగ్యానికి ప్రాధాన్యత ఇచ్చే విషయంలో చాలా దేశాలాలో ఒక వైద్య విధాన మంటూ ఉందా అన్నది మరోసందేహం. ఇప్పటికీ చాలా దేశాలు తమ దేశాలాలో సమగ్ర ఆరోగ్య విధానం రూపొందించు కోక పోవడం దురదృష్ట కరం. దీనినిబట్టి మరో ప్యాండమిక్ వస్తే తప్ప ప్రజా ఆరోగ్యానికి మోక్షం లేదన్నది వాస్తవం.
read moreఅడెనోవైరస్ ఇన్ఫెక్షన్స్...
అడెనోవైరస్ ఇన్ఫెక్షన్స్ వివరణ... అడెనో వైరస్ కు కారణం శ్వాసససంబందిత అనారోగ్యమే.కాని గ్యాస్ట్రో ఎట్రోఎంట్రయి టిస్ ,కంజ క్టివైటిస్ ,సైస్టిటిస్ ,రాష్ తో కూడిన అనారోగ్యం ఎక్కువగా జన సమూహం లో ఉండడం వల్ల ఒత్తిడి ,అడెనో వైరస్ ఇన్ఫెక్షన్ కు కారణం గా పేర్కొన్నారు.దీనిని ఈరకమైన డిజార్దర్ ఏ క్క్యుట్ రె స్పిరెట్రి డిసీజ్ దీనిని వైద్య పరిభాషలో ఏ ఆర్ డి అంటారు. ఎక్యుట్ రె స్పిరేటరీ లక్షణాలు... అడేనో వైరస్ ఇన్ఫెక్షన్ నులక్షణాలను బట్టి విభజించారు.సహజంగా జలుబు,నిమోనియా, బ్రోన్ కైటిస్ గా విభజించారు.అడెనో వైరస్ ఒకరి నుంచి ఒకరికి చేరుతుంది.నోటి ద్వారా,ఆయా సందర్భానుసారానని అనుసరించి నీటిద్వారా వ్యాప్తి చెందుతుంది. ఎక్యుట్ రెస్పిరేట్రి ఇన్ఫెక్షన్ నిర్ధారణ పరీక్ష... అడెనోవైరస్ ఇన్ఫెక్షన్ క ల్చర్ టెస్ట్,రక్తం లో యాంటి బాడీఎంతశాతం ఉంది అన్న పరీక్ష చేసి వైరస్ శాతం ఎంత ఉందొ నిర్ధారించి సమస్యను గుర్తించి చికిత్స చేస్తారు. అడెనోవైరస్ ఇన్ఫెక్షన్ కు చికిత్స... చాలా మట్టుకు ఇన్ఫెక్షన్ లకు లక్ష నాళను బట్టి చికిత్స చేస్తారు అది స్వల్ప ప్రభావం తో కూడిన మందు లనే వాడతారు
read moreప్రాసెస్డ్ ఆహారంతో రెండోసారి హార్ట్ ఎటాక్...
యు పి ఎఫ్ అల్ట్రా ప్రోసెస్డ్ ఫుడ్ ఫార్ములాతో ప్రత్యేకంగా వండిన ఆహారం వల్లే గుండెకు సంబందించిన సమస్యలకు కారణం అవుతుంది.ఇందులో వాడే ఇంగ్రీడియంట్స్ మొత్తం ఆహారం లో ఉండడం వల్ల దీనిప్రభావం తీవ్రంగా ఉంటుందని నిపుణులు హెచ్చరిస్తున్నారు. ఇటీవల్ జరిగిన పరిశోదనలో అల్ట్రా ప్రోసెస్డ్ ఫుడ్ వల్ల గుండెకు సంబందించిన సమస్యలు మళ్ళీ వచ్చే అవకాశం ఉందని హెచ్చరిస్తున్నారు. ఇది రక్త నాళాల పై తీవ్ర ప్రభావం చూపుతుంది. ఒక నూతన పరిశోదన ప్రకారం ఆహారం ప్రత్యేకంగా తీవ్ర ప్రభావం ఉంటుందని,ఒకసారి గుండె సమస్య వచ్చి తగ్గిత్తే మళ్ళీ వచ్చే అవకాశం ఉందని పరిశోధకులు వెల్లడించారు. ఆహారం మొత్తం లో లేదా అందుకు వాడే ఇంగ్రీడియంట్స్ లేదా దినుసులు 5 కంటే ఎక్కువ వాడరాదు. తరచుగా ఖర్చులేని ఆహారపు ఉత్పత్తులు అనుగుణంగా అల్ట్రా ప్రోసేసేడ్ ఫుడ్ కు అనుగుణంగా మార్చడం జరుగుతుంది. ఇప్పటికే అల్ట్రా ప్రోసేస్సేడ్ ఫుడ్ వల్ల అనర్ధాలు తప్పవని శాస్త్రజ్ఞులు వివరిస్తూ వచ్చారు. దీర్ఘ కాలం తరువాత గుండె సంబంధిత సమస్యలకు కారణం అవుతోంది. కార్డియో వాస్క్యులర్ డిసీజ్ కు కారణం అవుతోంది. అని నిపుణులు తెలిపారు. ఒక నూతన పరిశోదనలో యు పి ఎఫ్ వాడకం వల్ల గుండేనొప్పి లేదా గుండె పోటుకు దారి తీయవచ్చు. ఈ విషయానికి సంబంధించి డాక్టర్ మారియా లారా బోనాకో ప్రజలు ఎక్కువ మొత్తం లో అల్ట్రా ప్రిసేస్ద్ వినియోగిస్తారో 2/3 వంతు మందిలో రెండవ సారి గుండెపోటు కు దారి తీయవచ్చు. ఈ పరిశోదనలో రెండవ సారి ఆహారాన్ని తక్కువ స్థాయిలో అంటే 6౦ % హైలీ ప్రోసేసేడ్ ఫుడ్ కావడం గమనించవచ్చు. ఈ విషయాన్ని దృవీకరిస్తూ యురోపియన్ హార్ట్ డిసీజ్ లో ప్రచురించారు. పరిశోదనలో ఎపిడమాలాజీ విభాగం ఐ ఆర్ సి సి ఎస్ న్యూరో పోజ్జిల్ ఇటలీ విష యం గుర్తించింది. అల్ట్రా ప్రోసేస్సేడ్ ఫుడ్ ను గుర్తించాలి .... యు పి ఎఫ్ అల్ట్రా ప్రోసేస్సేడ్ ఫుడ్ అంటే అందులో ఎ మాత్రం పోషకాలు ఉండవని కేవలం చాలా ఘాటుగా ఉంటుందని అయితే మరో మాటలో చేప్పాలంటే ఒకవేళ సమతులంగా ఆహారం ఉంటె అది ప్రాసెస్ చేసిందని చెప్పవచ్చు. కార్దియోలజి సమస్యతో బాధ పడే వారు తీసుకోవాల్సిన ఆహారం పై ఆ విభాగం డై టీ షియన్ మైకేల్ రూత్ స్టైన్ ఈ అంశం పై పరిశోదనలో పాల్గొనలేదు. చాలామంది తమ ఆహారం లో అత్యధికంగా కాలరీలు ఉండే విధంగా దృష్టి సారిస్తారని ఆహార పదార్ధం పై లేబుల్ పై ఉండే న్యుట్రీషియన్స్ ఉన్నాయా లేదా చూస్తారని దానిని మదింపు చేస్తారని అందుకే కొనుగోలు దారులు కొనే ముందు ఆహారం లో ఏమున్నాయో పూర్తిగా వివరాలు తెలుసుకోవాలి. రూత్ స్టన్ మాట్లాడుతూ ఆహారం లేబుల్ ను చూడడం ద్వారా కొంత వరకూ సహాయ పడుతుంది. అందులో ఎ ఇంగ్రీడియన్ ఉన్నాయో చదవాలి.నోవా క్లాసిఫికేషన్ లో చూడాలి. అల్ట్రా ప్రోసేస్సేడ్ ఫుడ్ ను నాలుగు విభాగాలుగా విభజించారు.... గ్రూప్1 --- ఈ విభాగంలో ప్రాసెస్ చేయని,లేదా చాలా తక్కువగా ప్రాసెస్ చేసిన లేదా అసలు ప్రాసెస్ చేయని ఉడక పెట్టిన లేదా పేస్తో రైజేడ్ చేసిన ఆహారం ఉండవచ్చు. గ్రూప్ 2 ---ఈ గ్రూప్ లో కల్నరీ ప్రాసెస్ చేసిన ఇంగ్రీడియంట్స్ అధికంగా వాడి ఉండవచ్చు. లేదా గ్రూప్ వన్ లో ఉన్న ఆహారం కావచ్చు. నూనె,ఉప్పు, మ్యాపుల్ సిరప్ ఇతర దినుసులు ఈ విధంగా గ్రూప్ ఒక్కో గ్రూప్ లో ఒక్కోరకమైన ఆహారం తయారు చేస్తారు. గ్రూప్౩ --- ఈ గ్రూప్ లో కొన్ని సార్లు బ్రెడ్ లేదా వెన్న ఇతర దినుసులు లేదా గ్రూప్ 1,2 లో వాడిన దినుసులు వాడవచ్చు. గ్రూప్ 4 ----ఇందులో ఇతర డ్రింక్స్ కలుపితారు,త్వరాగా ఉడకడానికి వైన్, కలపడం వల్ల ఆహారం రుచికరంగా ఉండేందుకు రక రకాల కొవ్వు పదార్ధాలు నిల్వ ఉంచే ఇతర రసాయనాలు ఫుడ్ కలర్ కృత్రిమ సువాసనలు. రీఫైండ్ చేసిన దినుసులు,సాఫ్ట్ డ్రింక్స్, స్వేట్స్, ఇతర రకరకాల్ ఆహార పదార్ధాలు ఆహారం లేదా మాంసము విచ్చుకున్న ఆహారం కావచ్చు. ప్రభావం తక్కువ స్థాయిలో మరణాలు యు పి ఎఫ్ లో పోషక విలువలు ఆహారం తోనే ముప్పు. అన్న విషయాన్ని గ్రహించాలని రెండవ సారి హార్ట్ అట్టాక్ వచ్చే అవకాసం ఇవ్వరాదని తెలుస్తోంది.
read moreచిన్న నిర్లక్ష్యం భారీ మూల్యం!!
ప్రపంచంలోని 57 దేశాలలో వ్యాపించిన ఓమైక్రాన్ చిన్న నిర్లక్ష్యం ప్రమాదకారిగా మారవచ్చు ప్రపంచ ఆరోగ్య సంస్థ హెచ్చరించింది. ఇప్పటికే ప్రపంచం వ్యాప్తంగా వ్యాపించిన ఓమైక్రాన్ వేరియంట్ 5 7 దేశాలకు విస్తరించిందని డబ్ల్యు హెచ్ ఓ ప్రకటించింది. అయితే ఒమైక్రాన్ డెల్టా వేరియంట్ కంటే తక్కువ ప్రబావం కలిగిఉందని గుర్తించినట్లు డబ్ల్యు హెచ్ ఓ ప్రకటించింది. చాలా దేశాలకు విదేశాల నుండి వచ్చిన ప్రయాణీకుల వల్లే వ్యాప్తి చెందిందన్న విషయాన్నిస్పష్టం చేసింది. డబ్ల్యు హెచ్ ఓ డైరెక్టర్ టేడ్రోల్ అద్నం గేబ్రియల్ మాట్లాడుతూ ఒమైక్రాన్ వ్యాప్తి ఉందన్న విషయం స్పష్ట మైంది అని అన్నారు. ఒమైక్రాన్ విస్తరణ నివారణకు దేశాలు సమగ్ర చర్యలు చేపట్టడం ద్వారా ఆసుపత్రుల లో చేరుతున్న వారి సంఖ్యను తగ్గించవచ్చని అభిప్రాయ పడ్డారు. అన్ని దేశాలు దీనిపై దృష్టి పెట్టాలని గేబ్రియల్ సూచించారు. టెస్టింగ్ ట్రేసింగ్ పరీక్షలు సీక్వెన్సింగ్ పెంచాల్సిన అవసరం ఉందని గే బ్రియల్ స్పష్టం చేసారు. కాగా ఒక చిన్న నిర్లక్ష్యం కొంచం కాదు భారీ మూల్యం చెల్లించక తప్పదని ఆయన హెచ్చరించారు. ప్రపంచ ఆరోగ్య సంస్థ వారాంతపు సమీక్షలో భాగం గా సమర్పించిన రెపొర్ట్ లో ఒమైక్రాన్ వేరియంట్ ప్రభావం గానంకాల వివరాలను తప్పనిసరిగా నమోదు చేయాల్సిన అవసరముందని అన్నారు.కాగా ఆరోగ్యశాఖ సంస్థలు మాత్రం డెల్టా వేరియంట్ ప్రభావం కన్నాఒమైక్రాన్ తీవ్రత తక్కువగా ఉంటుందని ఆసుపత్రులలో రోగుల సంఖ్య పెరగవచ్చని ఎందుకంటే త్వరిత గతిన వ్యాప్తి చెందడం ఆందోళన కారమని ముందు జాగ్రతగా చర్యలు చేపట్టడం ద్వారా ఒమైక్రాన్ తీవ్రతను తగ్గించేందుకు ప్రయాత్నం లో భాగం గా చర్యలు పూర్తిగా వ్యాక్సిన్ వేసుకోవాలని సూచించింది.
read moreకోవిడ్19 నిర్మూలనకు అయుష్ లో పరిశోధన
కేంద్రం అనుమతి రాజ్య సభలో అయుష్ మంత్రిత్వశాఖ పరిశోదన ల పై ఆడిన ప్రశ్నకు కేంద్రఅయుష్ మంత్రిత్వ శాఖ మంత్రి మహేంద్ర భాయి ముజఫర్ రాజ్య సభకు రథ పూర్వక మైన సమాధానం ఇచ్చారు. ఈ మేరకు కేంద్ర మంత్రి సమాధాన మిస్తూ శాస్త్రవేత్తలు,సంస్థలు,అసుపట్గ్రులు,ఆయా రాష్ట్రాల అయుష్ విభాగాలు ఆయుష్కు ఉపయోగ పడే అసేమ్ట మేటిక్,మైల్డ్,మోడరేట్ ఇన్ఫెక్షన్ల నివారణకు ప్రత్యామ్నాయ వైద్యంగా పరిశోదనలు చేయాలని నిర్ణ యించినట్లుకేంద్రమంత్రిత్వ శాఖ పేర్కొంది. రాష్ట్రాలు,కేంద్ర పాలిత ప్రాంతాలు,లైసెన్స్ అధారితీకి ఆదేశాలు ఇచ్చినట్లు పేర్కొన్నారు.ఈమేరకు డ్రగ్ కొంట్రోలర్లు అనుమతులు కలిగి ఉన్న మందుల ఉత్పత్తి దారులు అయుష్ 64 వ చట్టం కింద అనుమతులు ఇవ్వాలని లిఖితపూర్వక సమాధానం లో స్పష్టం చేసారు.ఆయా రాష్ట్రాలు వారి వారి పరిధిలో అసిమ్ప్త మటిక్ ,మైల్డ్,మోడరేట్ కోవిడ్ 19 కు ఈ అంశం పై అడిగిన ప్రశ్నకు సమాధాన మిచ్చారు. కోవిడ్ నియంత్రణలో భాగం గా ఆయుష్ మంత్రిత్వ శాఖ అయుష్ ఇంటర్ డి సిప్లినరి,అయుష్ రీసెర్చ్ అండ్ డవలప్మేంట్ టాస్క్ ఫోర్స్కు చిమన్ గా ప్రొఫెసర్ పట్వర్ధన్,శాస్త్రజ్ఞులు,పరిశోధకులు,ఐ సి ఎం ఆర్ సభ్యులు ఏ.ఐ .ఎం.ఎస్ కు చెందిన సభ్యులుఆయుష్ సభ్యుల ను నియమించ్జినట్లు మంత్రి సభకు వివరించారు. ఆరోగ్య శాఖ సహకారం తో ఆఉయుష్ శాఖ ఒక పరిశోదన చేసిందని తెలిపారు.కేంద్ర ప్రభుత్వ ఆరోగ్య కుతుంబ సంక్షేమం,మినిస్ట్రీ ఆఫ్ సై,న్స్ మినిస్ట్రీ ఆఫ్ టెక్నాలజీ,డిపార్ట్ మెంట్ ఆఫ్ సైన్సెస్,వివిధ రాష్ట్రాల అసుపత్రులతో కూడిన సభ్యుల బృందం నియమించి నట్లు అయుష్ శాఖా స్పష్టం ప్రకటన.
read moreన్యుమోనియా కారణాలు చికిత్స ...
ఊపిరి తిత్తుల ఇన్ఫెక్షన్ సోకి వాచిపోయి నొప్పిని కలగ చేయడమే న్యుమోనియా అని అంటారు. న్యుమోనియా వల్ల ఇంగ్లండ్ లో 27,౦౦౦ మంది చనిపోతున్నారని ఒక అధికారిక అంచనా.సాధారణంగా శరీరంలో మరేదో సీరియస్ జబ్బుకు కాంప్లికేషన్ గా నిమోనియా వస్తుంది.బ్యాక్టీరియా,వైరస్ లు,ఫంగి,వంటి విష పదార్ధాలు ఊపిరి తిత్తుల్లో కి ప్రవేశించి వాటికీ ఇన్ఫెక్ట్ అయినప్పుడు అవి వాచీ ఆవ్యక్తిలో న్యుమోనియా ఏర్పడుతుంది.న్యుమోనియలో రెండు రకాలు ఉన్నాయి. 1.లోబార్ న్యుమోనియా 2. బ్రాంకో న్యుమోనియా బ్రాంకో న్యుమోనియా లో లోబార్ న్యుమోనియా లో ప్రారంభ దశలో ఊపిరి తిత్తికి సంబంధించి న ఏదైనా ఒక లోబ్ ఇన్ఫెక్ట్ అవుతుంది.అభివృద్ధి చెందిన దేశాలలోఇది చ్సలా అరుదు.బ్రంకో న్యుమోనియాలో బ్రాంచి లో గాని వాపు ప్రారంభమై తర్వాత అది ఊపిరి తిత్తులోకి కాన సముదాయానికి వ్యాపిస్తుంది. న్యుమోనియా ఎంతకాలం ఉంటుంది? బ్యాక్టీరియా మూలంగా వచ్చే న్యుమోనియా ను సరైన యాంటిబయాటిక్ మందులతో ట్రీట్ చేస్తే వరం పదిరోజులలో తగ్గిపోతుంది. అయితే వైరస్ వాళ్ళ వచ్చ్చే న్యుమోనియా అంతసీరియస్ కాదు.,మందులు అంతగా పనిచేయవు. వారం రోజులలో దానికి అదే తగ్గిపోతుంది. ఈ రెండు రకాల న్యుమోనియా లో పూర్తిగా స్వస్థత పొందడానికి రెండు మూడు వరాల సమయం పడుతుంది. న్యుమోనియా కారణాలు... న్యుమోకోకస్ ,స్టెపిలోకోకస్వంటి బ్యాక్టీరియా మూలంగా వస్తుంది. వైరస్ ల మూలంగా వచ్చే న్యుమోనియా కి చికెన్ పొక్ష్ వైరస్ లు న్యుమోనియా లక్షణాలు ... న్యుమోనియా లో విడవకుండా పొడి దగ్గు. తీవ్రమైన జ్వరం,ఎగ శ్వాస,దిగ శ్వాస వస్తుంది. చాతిలో నెప్పి ఒకసారి చాతికి ఒక వైపునేనొప్పి ఉంది శ్వాస పీలుస్తున్నప్పుడు,దగ్గు తున్నప్పుడు ఎక్కువ అవుతుంది. జ్వరం చలి,పొడి దగ్గు కఫం ఉండదు కానీ ఏ కొద్దిగా ఉన్నా తెమడ వస్తే అందులో ఎర్రగా రక్తపు చరాలు కనిపిస్థాయి. శ్వాస ఇబ్బందిగా ఉంటుంది.నీరసం,అలసట, తలనొప్పి,తేమలటం వాంతులు,చిన్న పిల్లలో వ్యాధి లక్షణాలు అంతగా కనిపించవు,దగ్గు కొద్దిగా ఉండచ్చు.అసలు ఉండకనూ పోవచ్చు.బాగా జ్వరం డొక్కలు లోపలి పోతూ ఎగశ్వాస,దిగ శ్వాస ఉంటె మాత్రం పిల్లలో న్యుమోనియా తీవ్రంగా ఉన్నది అనడానికి సూచనగా చెప్పవచ్చు. న్యుమోనియా ఎవరికీ వస్తుంది... వృద్ధులకు,వారిలో రోగ నిరోధక శక్తి తక్కువగా ఉంటుంది కాబట్టి వారికి న్యుమోనియా రావచ్చు. వేరే ఇతారత్ర కారణాల వాళ్ళ ఆసుపత్రిలో చేరిన వారికి న్యుమోనియా వస్తుంది. సిగరెట్టూ తాగే వాళ్ళకి, మద్యం సేవించే వాళ్ళకి,పోషకాహారం లోపం ఉన్నవారికి,వైరల్ ఇన్ఫెక్షన్తో బాధ పడే వారికి, క్రానిక్ బ్రాంకైటిస్ లేదా ఎంఫి సేమా,రాకత హీనత ఉన్న వారికి,రేడియో తెరఫీ, కీమో తెరఫీ తీసుకుంటున్న క్యాన్సర్ రోగులకు దీనివల్ల రోగులలో రోగనిరోదక వ్యవస్థ బలహీన పరుస్తాయి.ఎయిడ్స్ తో బాధ పడే వారికి అన్నిరకాల వ్యవస్థలకు న్యుమోనియా సోకే అవకాసం ఉంది. న్యుమోనియాను ఎలా నిర్ధారిస్తారు... ఛాతీ,ఎక్సరే కఫం విశ్లేషణ రక్త పరీక్ష ద్వారా న్యుమోనియా బ్యాక్తీరియా కు సంబందించినద కాదా లేక వేరే బ్యాక్టీరియా అన్న విషయంలో డాక్టర్లు ఒక నిర్ధారణకు వచ్చి అందుకు అనుగుణంగా మందులను రాసి ఇస్తారు. న్యుమోనియా చికిత్స... సరిపడా బెడ్ రెస్ట్ తీసుకోవాలి.ఆవిరిని పీల్చడం పుష్కలంగా ఫ్లుఇడ్స్ తీసుకోవాలి.జ్వరం ఇతర సంబందిత సమస్యలకు డాక్టర్ను సంప్రదించాలి.టాబ్లెట్లను ఇవాలి బ్యాక్టీరియా మూలంగా వచ్చిన న్యుమోనియా అయితే డాక్టర్ రాసిన యాన్తి బాయితిక్స్ ని రాసి ఇస్తారు. ముక్కు దిబ్బడ వేస్తే ముక్కులో డ్రాప్స్ స్ప్రే కాంతివి డాక్టర్ సూచన మేరకు వాడాలి.కఫం లేని దగ్గు ఉంటె దగ్గు మందులు.కఫం తో కూడుకున్న దగ్గుకు మరో మందును డాక్టర్ సూచన మేరకు వాడాలి న్యుమోనియా ప్రమాదమా... న్యుమోనియా వ్యాధి గ్రస్తులు సహజంగా రెండు వారాలలో కోలు కుంటారు.వృద్ధులు కాస్త బలహీనంగా ఉన్నవారు ఊపిరి తిత్తుల కణ జాలం చికిత్సకు లొంగక పోతే క్రమేపీ తగకుంటే ఊపిరి తిత్తులు దెబ్బ తిని రేస్పిరేటరీ ఫైల్యూర్ తో చనిపోయే అవకాశాలు ఉన్నాయి.
read moreరెడ్ లైట్ తెరఫీ తో కంటి చూపు మెరుగు...
మూడు నిమిషాలు ఎర్రటి కాంతిని చూస్తే కంటి చూపు మెరుగు పడుతుంది. ఒక పరిశోదనలో ఎర్రటి కాంతిని లైట్ ను చూస్తే కంటి చూపు తగ్గుతుందని వస్తున్న ప్రచారంలో వాస్తవాన్ని తెలుసుకునేందుకు ఒక పరిశోదన చేపట్టారు. మనం వాడే ఎర్రటి లైట్ మైటో కాన్ డ్రియా రెటీనా పై పడుతుంది.మైటో కాన్ డ్రియా ఒక రకమైన కణాలు అవి శక్తి నిస్తాయి. లండన్ యునైటెడ్ కింగ్ డం కు చెందిన కాలేజ్ ఆఫ్ లండన్ సరైన లైట్ ఉంటె కంటి చూపు తగ్గదని నిపుణులు కనుగొన్నారు ఈ పరిశోదనలో మూడు నిమిషాల పాటు ఎర్రటి కాంతి లేదా లైట్ ఉదయం వేళ వారానికి ఒక్కసారి తీసుకుంటూ వయస్సు ద్వారా సంక్రమించిన మందగించిన చూపు పెరుగుతుందని అంటున్నారు. ఈ మేరకు పక్షులు,ఎలుకల పై పరిశోదనలు చేసారు.ప్రోఫెసర్ గ్లెన్ జేఫ్ఫ్రి మాట్లాడుతూ జంతువుల పై ఎలాంటి ప్రభావం చూపుతుంది ఎర్రటి కాంతి తో కూడిన లైట్ ఒక అవసరం కోసం 67౦ నానోమీటర్లు దూరంలో అమరుస్తారు. రెటీ నల్ మైటో కాండ్రియా,,, ప్రొఫెసర్ జెఫ్రీ కంటి చూపు మెరుగు పడడం వంటి అంశం పై చేసిన పరిశోదన వాస్తవానికి లైట్ల ప్రభావం వల్ల మైటో కాండ్రియా వాటి ప్రాధాన్యత గురించి వివరించారు.కణాలు అత్యున్నత శక్తి వంతమైన సాధన మని మైటో కాండ్రియా కు చార్జర్ లా పనిచేస్తుందని అన్నారు.వయస్సు రీత్యా ఎవరి కైతే చూపు మండగిస్తుందో ఈ సాధనం ఉపకరిస్తుంది. 4౦ సంవత్సరాల తరువాత చూపు మండగిస్తుందని 7౦% ఏ టి పి తగ్గుతుంది. అయితే ఉన్న కణాలలో శక్తి లేకపోవడం వల్ల చూపు మందగిస్తుంది. ప్రొఫెసర్ జెఫ్రీ ఇచ్చిన వివరాల ప్రకారం కంటిలోపల మైటో కాంద్రియా పై లాభనష్టాల పై కొత్త పరిశోదనలు చేసారు. రెటీనా మై టో కాన్డ్ డ్రియా కాక మరే ఇతర అవయవం ఎక్కువ శక్తిని వినియోగిస్తుంది. దీనివల్ల చాలా సులభంగా అప్తికల్స్ సరైన లైట్ ద్వారా రేటినల్ మైట్రో కాండ్రి యా,మైటో కాండ్రియా లివర్,కిడ్నీ రెటీనా లో వయస్సుతో నిమిత్తం లేకుండా ఇతర అవయవాల కన్నా త్వరగా బలహీన పడేది రెటీనా మీరు ఏమి చూసారు అన్న ప్రశ్నకు సమాధానం దొరుకు తుంది. దీనిని రెడ్ లైట్ తెరఫీ గా పిలుస్తారు.దీనివల్ల కొంతమేర చూపు మెరుగు పడుతుంది. కలర్ కాంట్రాస్ట్ విజన్... స్త్రీ పురుషులలో చిన్న పరిశీలన 34 సంవత్సరాల నుండి 7౦ సంవత్సరాల ఉన్న వారిలో వస్తున్న మార్పులను వారి కలర్ కాంట్రాస్ట్ ఆధారంగా కంటి చూపును లెక్కించారు. ప్రారంభంలో రంగులలో వ్యత్యాసం అందరిలోనూ సాధారణ కలర్ కాంట్రాస్ట్ ఉందని గుర్తించారు. కలర్ కాంట్రాస్ట్ విజన్ మూడు గంటల పాటు పరీక్షించారు.దానికి ఎర్రటి లైట్ పై పరిశీలించగా మరో వారం తరువాత పరిశీలిస్తే మరల తిరిగి ఉదయం పరిశీలిస్తే 17% పెరిగింది. .
read moreదడ పుట్టిస్తున్న ఓమైక్రాన్...
భారత్ లో పెరుగుతున్న ఓమైక్రాన్ బాధితుల సంఖ్య ? భారత్ లో ఓమైక్రాన్ కేసుల సంఖ్య గణనీయంగా పెరుగుతున్నట్లు తెలుస్తోంది.తాజా సమాచారం ప్రకారం మొత్తం 6,822 కేసులు నమోదు అయినట్లు తెలుస్తోంది . వివరాలు ఆయారాష్ట్రాలలో ఈ క్రింది విధంగా ఉన్నాయి. రాష్ట్రాలు ఓమైక్రాన్ బాధితుల సంఖ్య కేరళా 3,277 తమిళ నాడు. 719 మహారాష్ట్ర 518 వెస్ట్ బెంగాల్ 465 మిజోరం 330 మరణాలు 220 అయారాష్ట్రాలలో చేపట్టిన చర్యల వివరాలు ఈ క్రింది విధంగా ఉన్నాయి. ఉత్తరప్రదేశ్.... ముఖ్యమంత్రి యోగి ఆదిత్య నాద్ ఆదేశాల మేరకు విదేశాల నుండి వస్తున్న వారికి ఇతరులకు ఆర్ టి పి సి ఆర్ పరీక్షలకు అధికార యంత్రాంగం సన్నద్ధమయ్యింది. అసుపాత్రుల లో మెరుగైన సేవలకు త్వరిత గతిన సౌకర్యాల ఏర్పాటుకు రంగం సిద్దం చేస్తున్నారు. తమిళ నాడు.... ముఖ్యమంత్రి స్టాలిన్ నేతృత్వం లోని ప్రభుత్వానికి ఓమైక్రాన్ నుండి ప్రజలను రక్షించు కోవడం పెద్ద సవాల్ గా మారింది. విదేశాల నుండి వచ్చే ప్రయాణీకులకు తప్పనిసరిగా ఆర్ టి పి సి ఆర్ పరీక్షలు ఓ మైక్రాన్ బాధితులకు ఇసోలేషణ్ చికిత్స. ప్రభుత్వ ఆసుపత్రులలో పడకల పెంపు. ఇప్పటికే 5,858 పరీక్షలు నిర్వహించగా, 5,249 హై రిస్క్ కేసులు గుర్తించారు. డిల్లి రాష్ట్రం.... డిల్లి కేజ్రీవాల్ నేతృత్వం లోని ఆప్ సర్కార్ గతం లో కోవిడ్ ప్రభావాన్ని చూసిన అనుభవం ప్రస్తుతం డిల్లి లోని పరిస్థితులను మంత్రి జైన్ సమీక్షించారు. గ్రేడేడ్ రెస్పాన్స్ యాక్షన్ ప్లాన్ సహకారం తో టెస్టింగ్,ట్రేసింగ్, ఇసోలేషణ్ విధానాని అమలు చేసేందుకు సన్నధం అవుతోంది. ప్రస్తుతం విదేశాల నుండి వచ్చే ప్రయాణీకులతో డిల్లి విమానాశ్రయం కిటకిట లాడుతోంది కాగా ఆర్ టి పి సి ఆర్ పరీక్షల కోసం ఘంటల తరబడి వేచిచూడాల్సి రావడం తో అటు అంతార్జాతీయ ప్రయాణీకులు డొమెస్టిక్ ప్రయాణీకులు తీవ్ర ఇబ్బందులు పడుతున్నారు. కాగా రెండవ విడత ప్రభావాన్ని దృష్టిలో ఉంచుకొని ఆప్ సర్కార్ మెరుగైన చికిత్సకు సన్నద్దం అవుతున్నట్లు తెలుస్తోంది . ప్రస్తుతం ఓమైక్రాన్ శాస్త్రీయత .... ఓమైక్రాన్ పై వస్తున్న కొన్ని సందేహాలకు సమాధానం దొరకడం లేదు. ఓమైక్రాన్ ప్రభావం స్వల్పంగా ఉంటుందా.లేక తీవ్రంగా ఉంటుందా,ఎలాంటి ప్రబావం ఉంటుంది,వ్యాదితీవ్రత ప్రభావం అనారోగ్యం ఉంటుంది అన్న సందేహాలకు పూర్తిగా సమాధానం లభించడం లేదు. గతంలో కోవిడ్ తీవ్రత ఇమ్యునిటీ పై ప్రభావం, వేరియంట్ తీవ్రత ప్రభావం వ్యాక్సినేషన్ ఒమైక్రాన్ ను నిలువ రించాగాలదా?సొత్ ఆఫ్రిక పరిశోదనలో ఓమైక్రాన్ వ్యాప్తి ఎక్కువే,లక్షణాలు స్వల్పమే,అయినా తక్కువస్థాయిలో వైద్యం అవసరం? ఎలాంటి చికిత్స ఇస్తున్నారు? ఎవరైతే వ్యాక్సిన్ తీసుకోలేదో వారిలోనే వైరస్ వచ్చిచేరుతోందా ? వైరస్ ఎలా వ్యాపిస్తుంది.? వైరస్ వచ్చిన యువతీ యువకులలో ఇన్ఫెక్షన్ శాతం ఎంత? చాలా ఆసుపత్రులలో స్వల్ప లక్షణాలు కనిపిస్తాయి. సౌత్ ఆఫ్రికాలో ఒమైక్రాన్ ఎలా ప్రవర్తిస్తోంది? అలాగే ఇతర దేశాలలో ప్రవర్తిస్తోంధా? ఒక్కోచోట జీనోమిక్స్ సీక్వెన్స్ ఎలాఉంది? జీనోమిక్ సీక్వెన్స్ లో ఎలాంటి తేడాలు ఉంటున్నాయి.? వ్యాక్సిన్ ఓమైక్రాన్ ను నియంత్రించ గలదా?అన్నసందేహాలు అటు సామాన్యుడితో పాటు ఇటు వైద్యులను వేదిస్తోంది. ప్రపంచ ఆరోగ్య సంస్థ ఇపాటికే వ్యాక్సిన్ కంపెనీలతో సంప్రదింపులు జరుపు తోంది. వ్యాక్సిన్లు తీవ్రతను తగ్గిస్తాయా? మరణాలను నిరోదిస్తాయా? ప్రస్తుతం ఒమైక్రాన్ విస్తరిస్తోంది. అన్న అంశం పై పరిశోదనలు జరుగుతున్నాయి. ఓమైక్రాన్ ఇన్ఫెక్షన్ స్తాయి. వ్యాక్సిన్ పనితీరు, ఓమిక్రాన్ నిర్ధారణ పరీక్షలు, ఓమైక్రాన్ కు చికిత్స ప్రభావం వంటి అంశాలపై దృష్టి పెట్టాల్సిన అవసరం వీటిపై సమాగ్రసమాచారాం అందించే బాధ్యత ఆయాదేశాలాడే అని ప్రపంచ ఆరోగ్య సంస్థ పేర్కొంది.
read more








.webp)




.webp)

.webp)


.webp)
.webp)